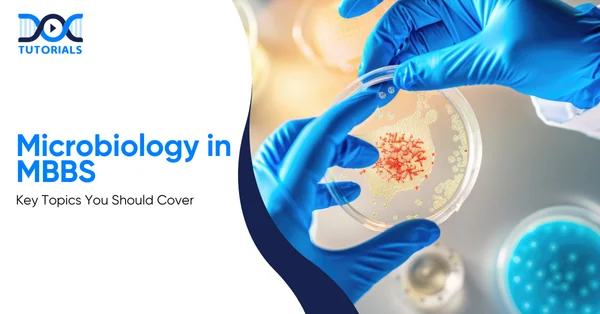
Microbiology Notes | DocTutorials

Microbiology in MBBS: Key Topics You Should Cover
Microbiology is a key subject in the MBBS curriculum, encompassing numerous concepts and serving as a vital bridge between the basic and clinical sciences. Due to the emergence of new pandemics worldwide, it has become mandatory to have an in-depth understanding of microbiology in MBBS.
Therefore, to score good marks in this subject, medical students need to prepare comprehensive microbiology notes and learn them with diligence. Keep reading for a detailed insight.
Why Microbiology is Important in MBBS?
Microbiology is a core MBBS subject that bridges rudimentary sciences with clinical practice, helping students understand the causes, diagnosis, and management of infectious diseases. It plays a vital role in everyday medical decision-making, from antibiotic selection to infection control.
The MBBS course, especially in the initial two years, consists of non-clinical and para-clinical subjects including Anatomy, Physiology, Biochemistry, Pathology, Pharmacology, and Microbiology.
These form the basis of learning clinical subjects in the latter two years of MBBS. Amongst them, Microbiology occupies a special position since it links basic sciences with practice. Microbiology teaches young doctors about microbes, including bacteria, viruses, fungi, and parasitic microbes, which cause most illnesses in humans.
From diagnosing infections to prescribing antibiotics and controlling infections, almost every clinical decision is influenced by microbiology. Another prime factor that brought the focus to microbial science was the emergence of the COVID-19 pandemic, which demonstrated the influence of a single microbe on global health and economies.
Although it is an extremely valuable field, many students find it overwhelming initially because of its vast syllabus, extensive memorisation, and laboratory components. But there is actually a way to turn this topic into a very interesting and scoring one.
What are the Essential Topics Covered in Microbiology in the MBBS Course?
Microbiology carries significant weightage in both theory and practical exams. Thorough preparation of core topics is essential to succeed in university and entrance examinations. Well-structured and regularly updated microbial notes help students stay exam-ready and confident.
Here are the key topics and chapters about which every MBBS student should work while preparing microbiology notes:
1. General Microbiology Module
- Contributions of Louis Pasteur
- Koch’s Postulates
- Bacterial cell wall
- Flagella
- Bacterial growth curve (a must-know topic)
- Anaerobic culture methods
- Antimicrobial susceptibility testing
- Horizontal gene transfer
- Antimicrobial resistance
- Exotoxin vs endotoxins
- Isolation techniques for viruses
- Classification with examples (parasites and fungi)
2. Immunology Module
- Innate immunity vs acquired immunity
- Active immunity vs passive immunity
- Definitions of antigen, hapten, and superantigens
- Structure of an antibody
- Various classes of immunoglobulins
- Monoclonal antibodies
- Basic mechanisms of precipitation reaction and agglutination reaction
- ELISA (in detail)
- MHC
- Cytokines
- Hypersensitivity reactions and their types
- Mechanisms and examples of autoimmunity
- Mechanism of graft rejection
- Types and examples of vaccines
Before you start reading the systems, there are sections on disinfection and sterilisation that have become more significant after COVID-19. These sections are very important as they will educate you on fundamental topics such as biomedical waste management, PPE kits, and more.
3. Disinfection and Sterilisation
- Healthcare-acquired infections (definition, and examples)
- The steps of hand washing (it rarely comes as a theoretical question, but hold importance)
- Types of masks
- Steps of donning and doffing
- CAUTI and VAP
- Definitions of sterilisation, disinfection, and cleaning
- Autoclave
- ETO
- Disinfectants (according to the levels)
- Methods to test the efficacy of the sterilant
- Colour coding of dustbins
- Definition and management of needle stick injury
- Water surveillance
4. Systemic Microbiology Module
Bloodstream and Cardiovascular Infections
- Acute rheumatic fever
- Infective endocarditis
- Brucellosis and leptospirosis
- Fuo
- Leishmaniasis
- Typhoid
- Scrub typhus
- Malaria
- Dengue
- HIV (in detail)
- Systemic candidiasis
- Lymphatic filariasis
- African sleeping sickness
Gastrointestinal Tract Infections
- Food poisoning
- Cholera
- Mechanism of diarrhoea and agents
- Lab diagnosis of diarrhoea
- Intestinal amoebiasis
- Botulism
- Ascariasis
- Giardiasis
- Trichura
- Types of E.coli
- Entrobias
- Shigella
- Rotavirus diarrhoea
- Intestinal taeniasis
- Hookworm
The Hepatobiliary System
- Hepatitis
- Liver abscess
- Hydatid cyst
Skin and Musculoskeletal System Infections
- Diabetic foot
- Gas gangrene
- Staph aureus infections
- HSV infections
- Streptococcus pyogenes infections
- VZV infections
- Lab diagnosis of leprosy
- Cutaneous leishmaniasis
- Measles
- Superficial mycoses
- Cutaneous larva migrans
Respiratory Tract Infections
- Pneumonia
- Agents of respiratory tract infections
- Diptheria
- Coronavirus
- Tb (a crucial topic for Indians, as this ailment is quite common in our country)
- Aspergillosis
- Influenza
- Infectious mononucleosis
CNS Infections
- Rabies, particularly the vaccine prophylaxis
- Sleeping sickness
- Cerebral malaria
- Meningitis
- Tetanus
Urinary Tract Infections
- Chancroid
- Syphilis
- Chlamydia infections
- Pathogenesis of UTI
- Agents of UTI
Miscellaneous Infections
- Oncogenic viruses
- Bite wound infections
- Congenital syphilis
- Zoonotic infections
FAQs about Microbiology in MBBS
- What are the major and exam-important topics of microbiology for MBBS?
Major topics include bacterial cell structure, toxins, sterilisation methods (autoclave, hot-air oven), antiseptics and disinfectants, and a detailed study of common pathogens.
High-yield organisms include Staphylococcus, Streptococcus, Mycobacterium tuberculosis, Enterobacteriaceae, Vibrio, and key parasites such as Plasmodium, Entamoeba, Giardia, Ascaris, Taenia, and Wuchereria, with emphasis on morphology, life cycles, pathogenesis, clinical features, and laboratory diagnosis.
- What competencies will an MBBS student attain through the learning of microbiology?
Microbiology enables MBBS students to acquire knowledge and develop positive attributes in diagnosing, treating, and preventing infections caused by microbes, based on careful laboratory testing and sensible antimicrobial use.
Microbiology also enables future healthcare practitioners to effectively deal with antimicrobial resistance and emerging infections.
- Why are microorganisms classified into bacteria, viruses, fungi, protozoa, and helminths in MBBS microbiology?
This classification into bacteria, viruses, fungi, protozoa, and helminths enables MBBS students to distinguish and recognise the characteristics and features of each type of bacteria.
These include its structure, life cycle, mode of transmission, and disease manifestations, all of which are critical for diagnosing and treating infectious diseases.
- Why are handwritten microbiology notes better than typed notes for learning microbiology?
When it comes to learning complex subjects like microbiology, handwritten learning is preferred more. This is because it ensures effective memory retention by stimulating higher-level brain activity than typing.
Conclusion
Microbiology has been a crucial subject for MBBS students owing to its complexity and difficulty to grasp and overcome. A well-designed set of microbiology notes, books, practical training, and advanced revision techniques is essential for MBBS students to perform well in their exams and studies.
To help students understand complex concepts and prepare well for exams, DocTutorials helps meet the needs of MBBS students. We offer 3D-animated lectures, complete syllabus coverage, exam-focused content, complimentary hardcopy notes, and structured mentorship through our “Microbiology Simplified” plan.
Join DocTutorials today and explore our MBBS curriculum to excel in your medical career!
Latest Blogs
-

9 Essential MBBS Preparation Tips for Success
Achieving the dream of becoming a doctor is not easy. You need to be determined and have the right mindset…




